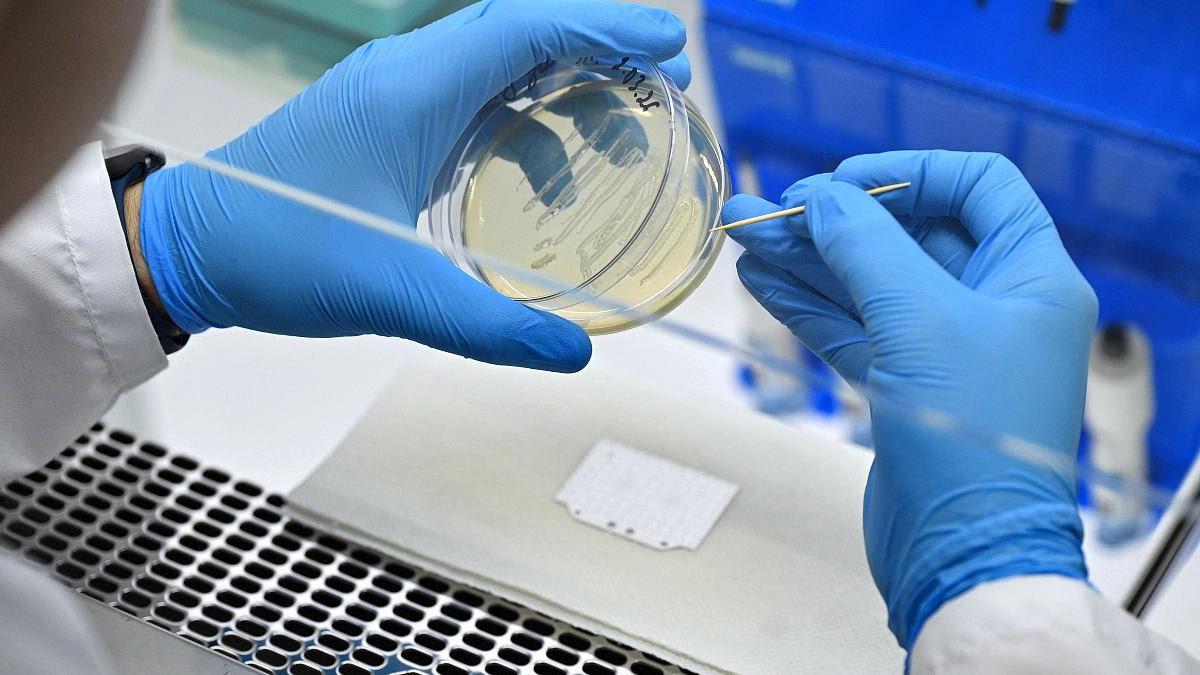
Ученые Мордовии предложили новаторский метод лечения грибковых заболеваний

Ученые Мордовии предложили новаторский метод лечения грибковых заболеваний
- 08:16 27 марта
- Руслан Савойский
Исследователи Мордовского государственного университета им. Н. П. Огарёва разработали новый подход к лечению грибковых заболеваний кожи и ногтей. Ключевое преимущество технологии — отсутствие системных побочных эффектов и предотвращение развития резистентности у патогенов.
В основе разработки лежат два компонента. Это природный фотосенсибилизатор на основе экстракта борщевика Сосновского. Вещество повышает чувствительность поражённых тканей к свету и портативное бифункциональное устройство, которое совмещает функции диагностики и терапии.
"Препарат наносится на поражённый участок кожи или ногтя с помощью шарикового роллера, после чего эта же зона облучается ультрафиолетовой лампой. Здоровые ткани при этом не затрагиваются", — пояснил инженер‑исследователь федерального центра развития биотехнологий и медицины МГУ им. Н. П. Огарёва Владислав Бобров.
Сейчас в МГУ им. Н. П. Огарёва готовят клинические испытания технологии. Успешное тестирование позволит предложить врачам и пациентам безопасную и эффективную альтернативу существующим схемам лечения.
Ранее мы писали, что в Саранске завершила работу республиканская медиашкола «ПАРА».
Фото: МГУ им.Н.П.Огарева
